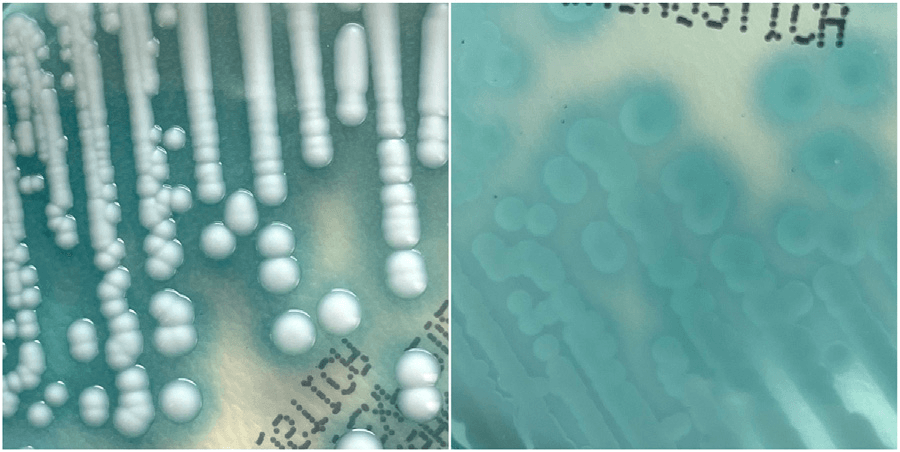
P286 | IICIMED

P288
Nat. Rev. Microbiol. 2024, 22, 636-649.
Healthcare as a driver, reservoir and amplifier of antimicrobial resistance opportunities for interventions.
https://doi.org/10.1038/s41579-024-01076-4

Structure activity relationship for antileishmanial activity and cytotoxicity.
P287
Eur. J. Med. Chem. Rep. 2024, 12, 100228.
Biological properties and in silico studies of thiazolopyrimidine derivatives active against visceral and cutaneous Leishmania spp. amastigote forms.
https://doi.org/10.1016/j.ejmcr.2024.100228.
Macroscopic appearance of C. auris colonies grown on CHROMagar Candida Plus medium. On the left: recto white colonies surrounded by a blue halo. On the right: verso pale blue colonies with blue halo.
P286
J. Mycol. Med. 2024, 34, 101490.
Current knowledge and practice of Candida auris screening in France: A nationwide survey from the French Society of Medical Mycology (SFMM).
https://doi.org/10.1016/j.mycmed.2024.101490

Synthesis of 6-aryl-2,4-diamino-1,3,5-triazines.
P285
Int. J. Pharm. Res. Al. Sci. 2024, 13, 1-11.
Design and synthesis of functionalized 2,4-diamino-1,3,5-triazines, potential inhibitors involved in immune and inflammatory response.
https://doi.org/10.51847/hsT2C61XWx

Response of C. parapsilosis to oxidative and osmotic stresses, cell wall disturbing agents, antifungal drugs, and metal toxicity.
P284
Nat. Commun. 2024, 15, 9190.
Alternative sulphur metabolism in the fungal pathogen Candida parapsilosis.
https://doi.org/10.1038/s41467-024-53442-8

Heteroresistance as a main driver of breakthrough bloodstream infections in allogeneic hematopoietic stem cell transplant (allo-HSCT) recipients.
P283
Trends Microbiol. 2024, 32, 1042-1044.
Heteroresistance: a hidden cause behind antifungal prophylaxis failure.
https://doi.org/10.1016/j.tim.2024.09.008

P282
Br. J. Anaesth 2024, 132, 197-200.
Role of anaesthesia providers in infection-related care across the perioperative pathway: a global survey.
https://doi.org/10.1016/j.bja.2023.10.023

P281
Clin. Microbiol. Infect. 2024, 30, 431-444.
Assessment of implementation strategies adopted for antimicrobial stewardship interventions in long-term care facilities: a systematic review.
https://doi.org/10.1016/j.cmi.2023.12.020

P280
Chem. Biodiversity 2024, e202300563
Chemical Composition, Antifungal, Antioxidant, and Hemolytic Activities of Morrocan Thymus capitatus Essential Oil.
https://doi.org/10.1002/cbdv.202300563

FRET assay setup for C. albicans HSP90–Sba1 or human HSP90α–p23 inhibitor screening.
P279
Pharmaceuticals 2024, 17, 516.
FRET Assays for the Identification of C. albicans HSP90-Sba1 and Human HSP90α-p23 Binding Inhibitors.
https://doi.org/10.3390/ph17040516

Relative membrane sterol composition (%) of C. parapsilosis ERG3 G111R/G111R strains compared with their parental relatives (ATCC 22019 and STZ5).
P278
Antimicrob. Agents Chemother. 2024, e0002224.
Precise genome editing underlines the distinct contributions of mutations in ERG11, ERG3, MRR1, and TAC1 genes to antifungal resistance in Candida parapsilosis.
https://doi.org/10.1128/aac.00022-24

Effect of inulin, pantoprazole and their combination on ESBL-E. coli fecal titers. Note. (a) Experimental design. (b) Individual and mean fecal titers of ESBL-E. coli.
P277
Gut Microbes 2024, 16, 2347021.
Efficacy of an inulin-based treatment on intestinal colonization by multidrug-resistant E. coli: insight into the mechanism of action.
https://doi.org/10.1080/19490976.2024.2347021